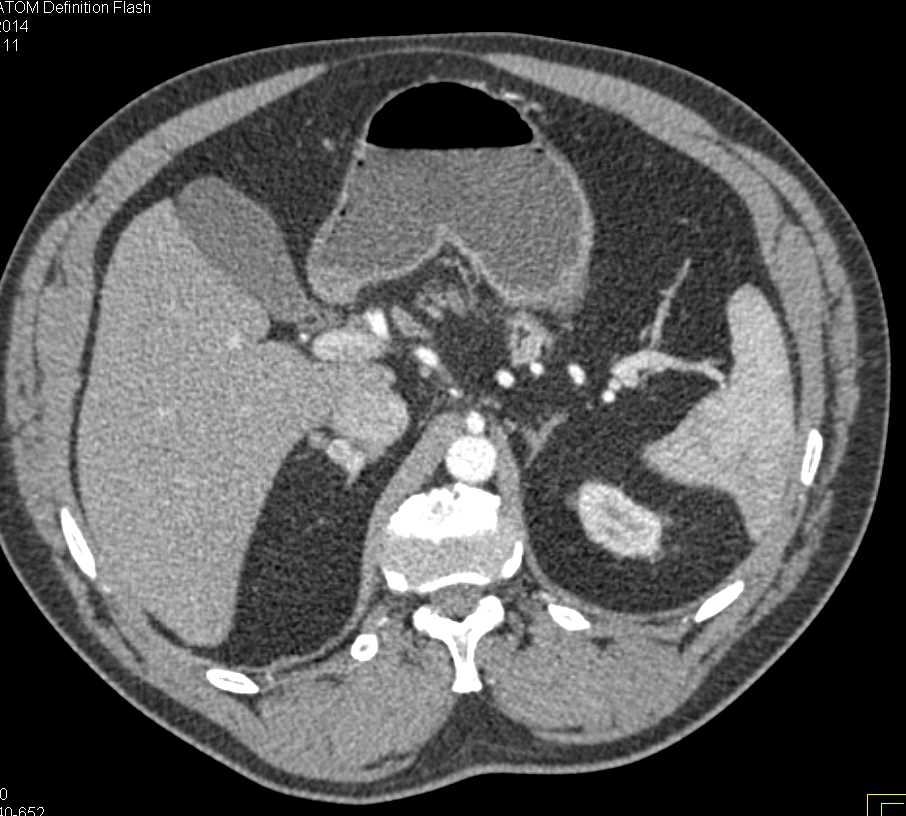

- 7
- ,
- 4
- 1
- 8
To Quiz Yourself: Select OFF by clicking the button to hide the diagnosis & additional resources under the case.
Quick Browser: Select ON by clicking the button to hide the additional resources for faster case review.
CASE NUMBER
535
Diagnosis
Enhancing Adrenal Glands in a Hypotensive Patient who Incidentally had Superior Mesenteric Artery (SMA) Syndrome
THIS IS CASE
535
OF
847